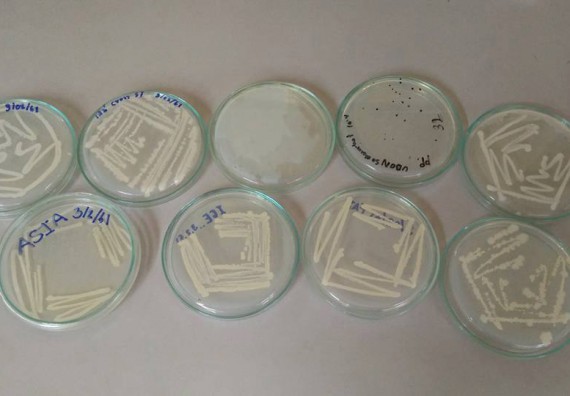
ภาพกิจกรรม โปรแกรมวิชาชีววิทยา จัดการอบรมเชิงปฏิบัติการ เรื่องการเพาะเลี้ยงเนื้อกล้วยไข่
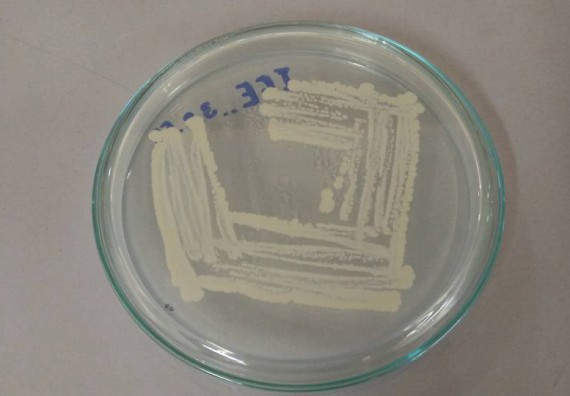
ภาพกิจกรรม โปรแกรมวิชาชีววิทยา จัดการอบรมเชิงปฏิบัติการ เรื่องการเพาะเลี้ยงเนื้อกล้วยไข่
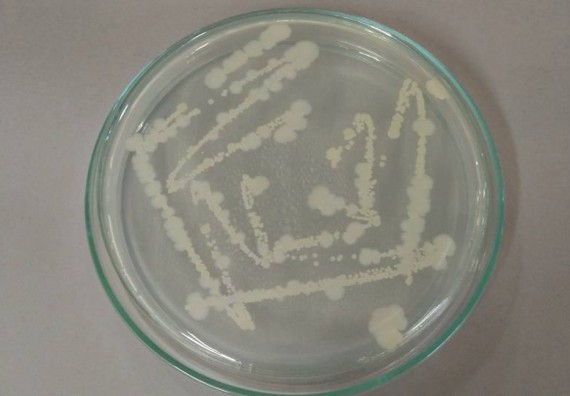
ภาพกิจกรรม โปรแกรมวิชาชีววิทยา จัดการอบรมเชิงปฏิบัติการ เรื่องการเพาะเลี้ยงเนื้อกล้วยไข่
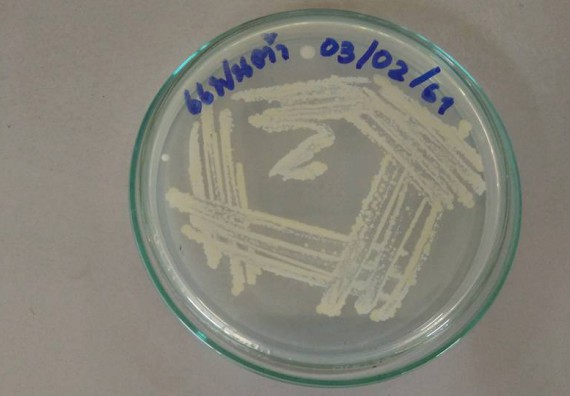
ภาพกิจกรรม โปรแกรมวิชาชีววิทยา จัดการอบรมเชิงปฏิบัติการ เรื่องการเพาะเลี้ยงเนื้อกล้วยไข่

โปรแกรมวิชาชีววิทยา จัดการอบรมเชิงปฏิบัติการ เรื่องการเพาะเลี้ยงเนื้อกล้วยไข่ ในวันที่ 4 กุมภาพันธ์ 2561 เวลา 08.00-16.30 น. ณ ห้องปฏิบัติการชีววิทยา อาคารจุฬาภรณวลัยลักษณ์ โดย อาจารย์ธนากร วงษศา ให้กับ นักเรียนโรงเรียนตากพิทยาคม จำนวน 30 คน วิทยากรโดย อาจารย์โปรแกรมวิชาชีววิทยา

งานพัฒนาสารสนเทศและงานประชาสัมพันธ์